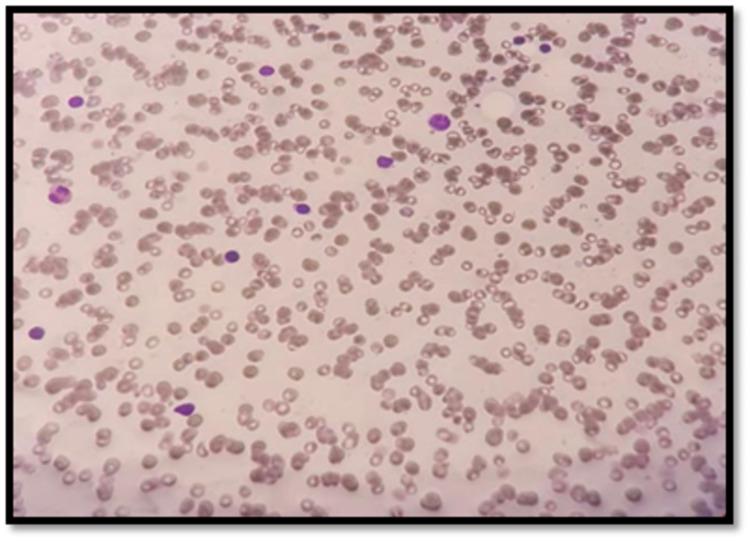

一名五岁男孩的遗传性血色素沉着症伴特发性难治性再生障碍性贫血:病例报告
Hereditary Hemochromatosis Associated With Idiopathic Refractory Aplastic Anemia in a Five-Year-Old Boy: A Case Report.
作者信息
Alharbi Ibrahim, Bahakim Abdullah K, Alharthi Sanad M, Alharthi Saad M, Baabdullah Abdulrahman A
机构信息
Pediatric Hematology Oncology, King Fahad Armed Forces Hospital, Jeddah, SAU.
Department of Pediatrics, Umm Al-Qura University, Makkah, SAU.
出版信息
Cureus. 2021 Dec 3;13(12):e20135. doi: 10.7759/cureus.20135. eCollection 2021 Dec.
Hereditary hemochromatosis (HH) is a multisystem disease characterized by iron overload and various clinical presentations, including cirrhosis, diabetes mellitus, and heart failure. HH can be caused by the human homeostatic iron regulator (HFE) and non-HFE gene mutations. Aplastic anemia is a rare, life-threatening bone marrow failure in which fat replaces pluripotent stem cells, resulting in pancytopenia and hypoplasia of bone marrow. We present a case of a five-year-old-boy who initially presented with a large ecchymosis located at the right side of the chest and abdomen. These started suddenly after minor trauma. Later, he was diagnosed with idiopathic aplastic anemia and treated with immunosuppressive therapy (IST). As part of the workup for pancytopenia, we ordered whole exome sequencing (WES) and diagnosed the patient with autosomal recessive hereditary hemochromatosis (ARHH). The ARHH is caused by HFE pathogenic gene mutation variant (c.187C>G p homozygous genotype). After six months of IST, he still had persistent disease. Human leukocyte antigen (HLA) typing showed he has a sister who is a full match but also has ARHH. Because of this, a haploidentical hematopoietic stem cell transplantation (hHSCT) from the father was performed. The hHSCT had a successful outcome. We suggest that in children with idiopathic aplastic anemia, physicians should be aware of the possibility of co-existing hereditary hemochromatosis or secondary hemochromatosis. Serum ferritin and transferrin saturation should also be measured regularly in order to detect early hemochromatosis.
遗传性血色素沉着症(HH)是一种多系统疾病,其特征为铁过载及各种临床表现,包括肝硬化、糖尿病和心力衰竭。HH可由人类铁稳态调节因子(HFE)和非HFE基因突变引起。再生障碍性贫血是一种罕见的、危及生命的骨髓衰竭疾病,其中脂肪取代了多能干细胞,导致全血细胞减少和骨髓发育不全。我们报告一例5岁男孩,最初表现为胸部和腹部右侧出现大片瘀斑,这些瘀斑在轻微创伤后突然出现。后来,他被诊断为特发性再生障碍性贫血,并接受了免疫抑制治疗(IST)。作为全血细胞减少检查的一部分,我们进行了全外显子测序(WES),并诊断该患者患有常染色体隐性遗传性血色素沉着症(ARHH)。ARHH由HFE致病基因突变变异(c.187C>G p纯合基因型)引起。经过6个月的IST治疗后,他的病情仍然持续。人类白细胞抗原(HLA)分型显示他有一个妹妹与之完全匹配,但也患有ARHH。因此,进行了来自父亲的单倍体相合造血干细胞移植(hHSCT),hHSCT取得了成功。我们建议,对于患有特发性再生障碍性贫血的儿童,医生应意识到可能并存遗传性血色素沉着症或继发性血色素沉着症。还应定期测量血清铁蛋白和转铁蛋白饱和度,以便早期发现血色素沉着症。